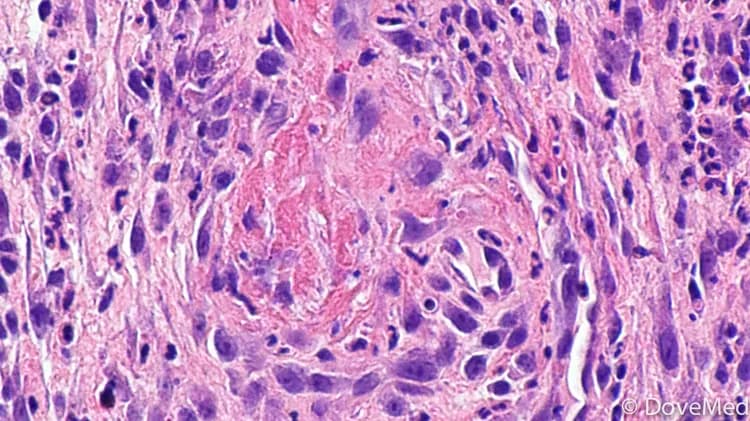
Image by Nephron - Wikicommons

What are the other Names for this Condition? (Also known as/Synonyms)
- Cardarelli Aphthae Infants
- Eosinophilic Granuloma of Soft Tissue
- Ulcerative Eosinophilic Granuloma
What is Traumatic Ulcerative Granuloma with Stromal Eosinophilia? (Definition/Background Information)
- Traumatic Ulcerative Granuloma with Stromal Eosinophilia (TUGSE) is a benign (non-cancerous) ulcer of the tongue and or oral mucosa. The ulcers most commonly form on the tongue, lips, or buccal mucosa (inner lining of the cheek)
- TUGSE can occur in individuals of all ages and is slightly more common in males than in females. When it occurs in infants, the condition is called Riga-Fede Disease. In infants, ulcers usually form due to trauma to the oral cavity caused by erupted baby teeth
- Biting, having sharp teeth, ill-fitting dentures, and broken fillings all are factors that increase one’s risk of developing Traumatic Ulcerative Granuloma with Stromal Eosinophilia
- The cause of Traumatic Ulcerative Granuloma with Stromal Eosinophilia is unknown. Trauma to the oral cavity is believed to contribute to its development, though it can occur without trauma too
- Use of a mouth guard and appropriate dental care, such as fixing broken fillings and using properly-fitting denture, can reduce one’s risk factors of TUGSE. In some cases, TUGSE can recur even after it has been resolved
- Traumatic Ulcerative Granuloma with Stromal Eosinophilia is a self-limiting condition. Surgical removal of the ulcer may be done in cases of long-standing TUGSE
Who gets Traumatic Ulcerative Granuloma with Stromal Eosinophilia? (Age and Sex Distribution)
- Traumatic Ulcerative Granuloma with Stromal Eosinophilia can affect individuals of all ages. Riga-Fede Disease is a subtype of TUGSE that exclusively affects infants
- The condition is slightly more common in males than in females
- No racial or ethnic preference is noticed
- It is seen all over the world; there is no particular geographical restriction
What are the Risk Factors for Traumatic Ulcerative Granuloma with Stromal Eosinophilia? (Predisposing Factors)
Risk factors of Traumatic Ulcerative Granuloma with Stromal Eosinophilia (TUGSE) include:
- Trauma to the oral cavity:
- Biting can damage the tongue, lips, and buccal mucosa (inside lining of the cheek)
- Sharp or irregular teeth can also damage the oral cavity
- Ill-fitting dentures can also result in oral cavity damage that can progress to TUGSE
- Broken fillings within the teeth can also increase the risk of developing TUGSE
- Sometimes, a risk factor is not identifiable
It is important to note that having a risk factor does not mean that one will get the condition. A risk factor increases one's chances of getting a condition compared to an individual without the risk factors. Some risk factors are more important than others.
Also, not having a risk factor does not mean that an individual will not get the condition. It is always important to discuss the effect of risk factors with your healthcare provider.
What are the Causes of Traumatic Ulcerative Granuloma with Stromal Eosinophilia? (Etiology)
- The exact cause and mechanism of Traumatic Ulcerative Granuloma with Stromal Eosinophilia (TUGSE) formation is currently unknown
- Injury to the oral cavity, usually of the tongue, lip, or buccal mucosa (inner lining of the cheek) is shown to contribute to the development of TUGSE. The injury may commonly occur due to biting, sharp teeth, or other dental problems
What are the Signs and Symptoms of Traumatic Ulcerative Granuloma with Stromal Eosinophilia?
The signs and symptoms of Traumatic Ulcerative Granuloma with Stromal Eosinophilia include:
- Ulcer formation on the tongue, lips, or buccal mucosa (inner lining of the cheek)
- The ulcer is irregular with rolled, elevated borders
- The base of the ulcer may have yellow exudate (fluid that comes out from the ulcer)
- The ulcer can sometimes project outwards, similar to a tumor
- Many individuals usually present with only one ulcer
- Ulcers may be associated with pain
- In infants (Riga-Fede Disease), it affects feeding and therefore causes dehydration, malnutrition, and failure-to-thrive if not treated promptly
How is Traumatic Ulcerative Granuloma with Stromal Eosinophilia Diagnosed?
Traumatic Ulcerative Granuloma with Stromal Eosinophilia (TUGSE) is diagnosed using the following tools:
- Thorough evaluation of the individual’s medical history and a complete physical and oral examination. An evaluation of medical history will determine if there is a presence of predisposing factors, such as biting or ill-fitting dentures
- Physical examination and clinical workup may uncover findings such as ulcer, irregular teeth, ill-fitting dentures, or broken fillings. Consultation with a dentist may be necessary
- In infants, evaluation by a neurologist may be necessary to rule out any associated neurological (brain, nerve) diseases
- Tissue biopsy is usually not necessary, but is performed when TUGSE recurs, if it has been present for many weeks, or shows no sign of healing
A tissue biopsy is the most definitive diagnostic tool to establish Traumatic Ulcerative Granuloma with Stromal Eosinophilia. In this procedure, the physician removes a sample of the oral cavity tissue and sends it to the laboratory for a histopathological examination. The pathologist examines the biopsy under a microscope. The pathologist arrives at a definitive diagnosis after a thorough evaluation of the clinical and microscopic findings, as well as by correlating the results of special studies on tissues (if required).
Many clinical conditions may have similar signs and symptoms. Your healthcare provider may perform additional tests to rule out other clinical conditions in order to arrive at a definitive diagnosis.
What are the possible Complications of Traumatic Ulcerative Granuloma with Stromal Eosinophilia?
The complications associated with Traumatic Ulcerative Granuloma with Stromal Eosinophilia (TUGSE) depend on the severity of the condition.
- Recurrence of the condition, if the risk factors are unresolved
- In infants, sometimes difficulty in feeding can result in dehydration, malnutrition, and failure-to-thrive
How is Traumatic Ulcerative Granuloma with Stromal Eosinophilia Treated?
The treatment options for Traumatic Ulcerative Granuloma with Stromal Eosinophilia (TUGSE) depend on the severity of the condition.
A typical treatment plan for an individual with TUGSE may include:
- Allowing time for the lesions to heal
- In some cases, corticosteroid ointment for the ulcer may be beneficial
- In some individuals, dental care may be required to correct or modify irregular sharp tooth, broken fillings, and ill-fitted dentures
- In some individuals, using a mouth guard to protect the oral cavity may be useful
- Surgical removal of the ulcer may be necessary, if conservative treatment measures have failed
- Post-surgical corticosteroid injections into the surgical site help decrease the risk of recurrence
Regardless of what treatment is recommended, follow-up care and regular screenings are important to ensure that TUGSE does not progress and cause further complications.
How can Traumatic Ulcerative Granuloma with Stromal Eosinophilia be Prevented?
The preventive measures of Traumatic Ulcerative Granuloma with Stromal Eosinophilia (TUGSE) include:
- Maintaining a good set of teeth that may be ensured by:
- Filing sharp teeth to protect the oral cavity against damage
- Using a mouth guard to help protect the tongue and buccal mucosa from damage, due to biting and teeth grinding while sleeping
- Replacing broken dental fillings
- Replacing poorly-fitting dentures
- TUGSE cannot be prevented if there are no obvious tooth (dental) concerns
It is not always possible to follow some of these preventative measures. Thus, it is important to attend regular medical and dental screenings, so that TUGSE can be detected early and suitably treated.
What is the Prognosis of Traumatic Ulcerative Granuloma with Stromal Eosinophilia? (Outcomes/Resolutions)
Most cases of Traumatic Ulcerative Granuloma with Stromal Eosinophilia (TUGSE) are self-limiting and resolve in weeks to months.
- There is a chance that TUGSE can recur, especially if risk factors like biting, ill-fitted dentures, or broken fillings are not properly addressed and resolved
- The prognosis of TUGSE is usually good, since it is benign and self-limiting. The ulcer usually heals within a few weeks by itself
Additional and Relevant Useful Information for Traumatic Ulcerative Granuloma with Stromal Eosinophilia:
Tissue biopsy: The biopsy may identify inflammation of the oral tissue that extends into deep tissue. The inflammatory cells are mixed which includes abundant eosinophils, lymphocytes, or histiocytes. Sometimes, atypical histiocytic granuloma (a collection of localized inflammatory cells) may be seen.
Related Articles
Test Your Knowledge
Asked by users
Related Centers
Related Specialties
Related Physicians
Related Procedures
Related Resources
Join DoveHubs
and connect with fellow professionals

0 Comments
Please log in to post a comment.